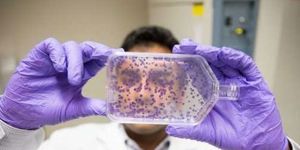
İnsan midesine ait dokular geliştirildi

- Meclis Genel Kurulu tamamlandı
- “Basın özgürlüğüne gerici müdahaleyi kabul etmiyoruz”
- Yargılanan kamusal figürlerin açık isim ve fotoğraflarını paylaşmak artık suç!
- Meclis Genel Kurulu’na ara verildi
- Serhat Akpınar: “KKTC günübirlik siyasetle 'taşınabilecek' bir noktada değil”
- 3 bin 500 dönüm orman arazisi İTÜ’ye devrediliyor
- Merkez Bankası TL kredi kartı faizini düşürdü, döviz faizini artırdı
- Sağlığa ilişkin protokol onay yasa tasarısı oy çokluğuyla geçti
- Uluslararası Pınar Çocuk Resim Yarışması'nın kazananları belli oldu
- Cumhurbaşkanlığı halka açık '1 Haziran Dünya Çocuk Günü' etkinliği düzenliyor